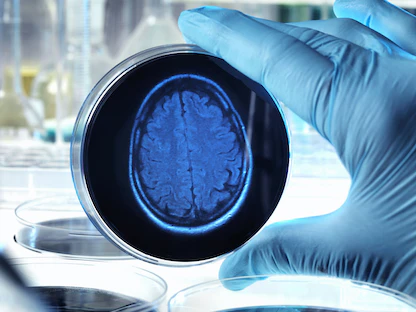
التهاب الدماغ.. أعراض تبدأ بـ"الصداع" وتنتهي بـ"الراحة"

أظهرت دراسة حديثة، نُشرت الأربعاء بمجلة "نيورولوجي" Neurology، أن التعافي من "التهاب الدماغ المناعي" Autoimmune Encephalitis الذاتي قد يستغرق أكثر من 3 سنوات، مما يبرز التحديات التي تواجه المرضى حتى بعد العلاج.
التهاب الدماغ المناعي الذاتي هو حالة نادرة يُسببها هجوم مناعي على الدماغ، ويصيب غالباً الشباب، ويبدأ بأعراض مثل الصداع، والتعب، والحمى.
ومع تطور المرض، تظهر أعراضاً أكثر خطورة تشمل فقدان الذاكرة، والتغيرات السلوكية، والهلوسات، والتشنجات، وحتى فقدان الوعي.
ويمكن أن يُشخَّص التهاب الدماغ المناعي بشكل خاطئ على أنه اضطرابات نفسية مثل الفصام، أو الاضطراب ثنائي القطب، مما يزيد من صعوبة العلاج المبكر.
وتُعتبر أورام المبيض، والتهاب الدماغ الناتج عن فيروس الهربس البسيط من بين الأسباب المعروفة لهذا المرض، على الرغم من أن معظم الحالات تظل بدون سبب واضح، ويمكن التداوي باستخدام العلاج المناعي، الذي يساعد غالبية المرضى على استعادة استقلاليتهم خلال عامين.
التهاب الدماغ المناعي
أُجريت الدراسة على 92 مريضاً في هولندا بمتوسط عمر 29 عاماً، حيث تمت مراجعة السجلات الطبية، وإجراء فحوصات عصبية ونفسية. وأظهرت النتائج تحسناً سريعاً في وظائف التفكير والذاكرة خلال الأشهر الستة الأولى، مع استمرار التحسن بوتيرة أبطأ حتى 3 سنوات.
وبعد 3 سنوات، ظل 34% من المشاركين يعانون من مشكلات معرفية، وسجَّل 65% أداء أقل من المتوسط في مجالات مثل الذاكرة واللغة.
وأفاد المشاركون باستمرار معاناتهم من مشكلات في الوظائف الاجتماعية، والصحة العاطفية، ومستويات الطاقة، وجودة الحياة.
فيما لم يتمكن 30% من المرضى من العودة للعمل أو الدراسة، بينما احتاج 18% منهم إلى تعديلات لاستئناف نشاطاتهم.
وتوفر الدراسة تصوراً أكثر واقعية للمرضى وأسرهم والأطباء حول رحلة التعافي، مما يساعد على إدارة توقعات الشفاء بشكل أفضل.
وأشارت النتائج إلى أهمية إعادة التأهيل المعرفي والاجتماعي كجزء من خطة العلاج، مما يساعد المرضى على استعادة وظائفهم في المجتمع بشكل أكثر فاعلية.
أسباب الإصابة بالتهاب الدماغ المناعي
يصاب الأشخاص بالتهاب الدماغ جراء عَدوى فيروسية أو بكتيرية، أو بسبب مهاجمة الخلايا المناعية الدماغ عن طريق الخطأ، وفق "مايو كلينك".
وبشكل أكثر تحديداً، يحدث التهاب الدماغ المناعي الذاتي عندما تهاجم الخلايا المناعية الدماغ عن طريق الخطأ، أو تنتج أجساماً مضادة تستهدف البروتينات والمستقبلات الموجودة في الدماغ، و"لم يفهم الباحثون بعد بصورة كاملة السبب الدقيق لحدوث ذلك".
وقد يحدث التهاب الدماغ المناعي الذاتي أحياناً بسبب الأورام الحميدة أو السرطانية، المعروفة باسم المتلازمات المصاحبة للورم في الجهاز العصبي، وقد تحدث الأنواع الأخرى من التهاب الدماغ المناعي الذاتي، مثل التهاب الدماغ والنخاع الحاد المنتثر (ADEM)، بسبب عدوى في الجسم.
ويُطلق على هذه الحالة التهاب الدماغ المناعي الذاتي التالي للعدوى، وفي كثير من الحالات، لا يكون السبب المحفز للاستجابة المناعية معروفاً، وقد يؤدي التهاب الدماغ أحياناً إلى الوفاة.